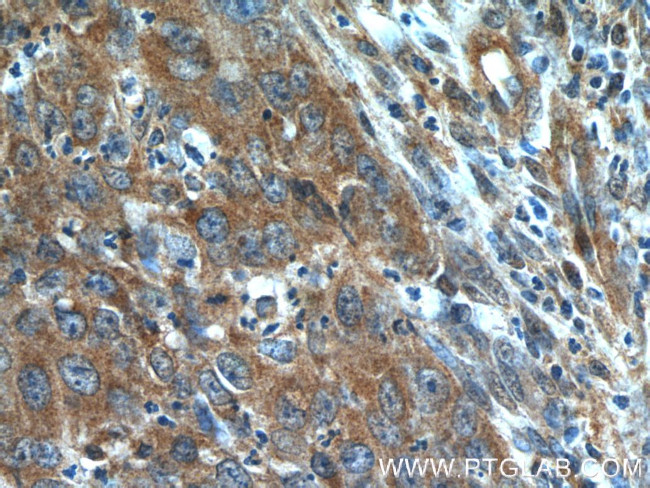
BLOC1S3 Antibody in Immunohistochemistry (Paraffin) (IHC (P))

Search
Proteintech
BLOC1S3 Polyclonal Antibody
{{$productOrderCtrl.translations['antibody.pdp.commerceCard.promotion.promotions']}}
{{$productOrderCtrl.translations['antibody.pdp.commerceCard.promotion.viewpromo']}}
{{$productOrderCtrl.translations['antibody.pdp.commerceCard.promotion.promocode']}}: {{promo.promoCode}} {{promo.promoTitle}} {{promo.promoDescription}}. {{$productOrderCtrl.translations['antibody.pdp.commerceCard.promotion.learnmore']}}
产品信息
25722-1-AP
种属反应
宿主/亚型
分类
类型
抗原
偶联物
形式
浓度
规格
纯化类型
保存液
内含物
保存条件
运输条件
产品详细信息
Immunogen sequence: MASQGRRRR PLRRPETVVP GEATETDSER SASSSEEEEL YLGPSGPTRG RPTGLRVAGE AAETDSEPEP EPEPTAAPRD LPPLVVQRES AEEAWGTEEA PAPAPARSLL QLRLAESQAR LDHDVAAAVS GVYRRAGRDV AALASRLAAA QAAGLAAAHS VRLARGDLCA LAERLDIVAG CRLLPDIRGV PGTEPEKDPG PRA (1-202 aa encoded by BC151152)
靶标信息
Component of the BLOC-1 complex, a complex that is required for normal biogenesis of lysosome-related organelles (LRO), such as platelet dense granules and melanosomes. In concert with the AP-3 complex, the BLOC-1 complex is required to target membrane protein cargos into vesicles assembled at cell bodies for delivery into neurites and nerve terminals. The BLOC-1 complex, in association with SNARE proteins, is also proposed to be involved in neurite extension. Plays a role in intracellular vesicle trafficking.
仅用于科研。不用于诊断过程。未经明确授权不得转售。
篇参考文献 (0)
生物信息学
蛋白别名: Biogenesis of lysosome-related organelles complex 1 subunit 3; biogenesis of lysosome-related organelles complex-1, subunit 3; BLOC-1 subunit 3; BLOS3; reduced pigmentation, mouse, homolog of; unnamed protein product
基因别名: BLOC1S3; BLOS3; HPS8; RP
UniProt ID: (Human) Q6QNY0
Entrez Gene ID: (Human) 388552